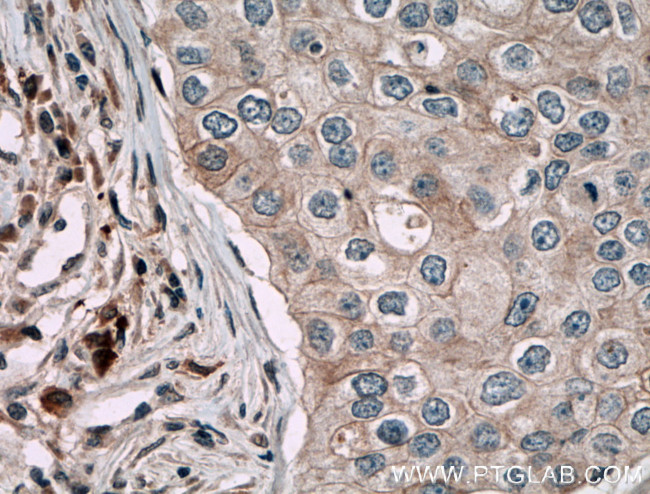
CARD14 Antibody in Immunohistochemistry (Paraffin) (IHC (P))

Search
Proteintech
CARD14 Polyclonal Antibody
{{$productOrderCtrl.translations['antibody.pdp.commerceCard.promotion.promotions']}}
{{$productOrderCtrl.translations['antibody.pdp.commerceCard.promotion.viewpromo']}}
{{$productOrderCtrl.translations['antibody.pdp.commerceCard.promotion.promocode']}}: {{promo.promoCode}} {{promo.promoTitle}} {{promo.promoDescription}}. {{$productOrderCtrl.translations['antibody.pdp.commerceCard.promotion.learnmore']}}
产品信息
10400-1-AP
宿主/亚型
分类
类型
抗原
偶联物
形式
浓度
规格
保存条件
运输条件
产品详细信息
Immunogen sequence: MGELCRRDS ALTALDEETL WEMMESHRHR IVRCICPSRL TPYLRQAKVL CQLDEEEVLH SPRLTNSAMR AGHLLDLLKT RGKNGAIAFL ESLKFHNPDV YTLVTGLQPD VDFSNFSGLM ETSKLTECLA GAIGSLQEEL NQEKGQKEVL LRRCQQLQEH LGLAETRAEG LHQLEADHSR MKREVSAHFH EVLRLKDEML SLSLHYSNAL QEKELAASRC RSLQEELYLL KQELQRANMV SSCELELQEQ SLRTASDQES GDEELNRLKE ENEKLRSLTF SLAEKDILEQ SLDEARGSRQ E (1-300 aa encoded by BC018142)
靶标信息
Membrane-associated guanylate kinase (MAGUK) family members localize to the plasma membrane and function as molecular scaffolds for the assembly of multi-protein complexes. The MAGUK family includes several mammalian proteins related to the Drosophila tumor suppressor discs-large (dlg) gene product, such as postsynaptic proteins, GKAPs, the tight junction associated proteins (ZO-1-3) and the caspase-associated recruitment domain (CARD) proteins: CARD 6, CARD 8-12 and CARD 14. CARD 14 is a 1,004 amino acid protein consisting of an N-terminal CARD domain, a central coiled-coil domain and a C-terminal tripartite domain comprised of a PDZ domain, an Src homology 3 domain and a GUK domain with homology to guanylate kinase. CARD 14 is expressed in the placenta where it positively regulates apoptosis. CARD 14 also controls NF-kappaB activation by phosphorylating BCL10, a signaling protein that activates NF-kappaB through the I kappaB kinase complex. Epigallocatechin-3-gallate (EGCG) is a polyphenol that induces the expression of CARD 14.
仅用于科研。不用于诊断过程。未经明确授权不得转售。